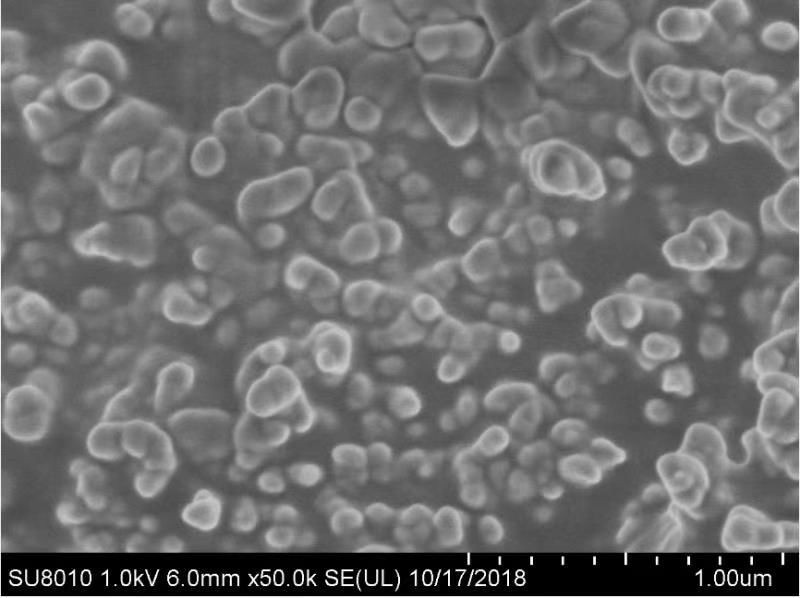

13 年
 白金會員
白金會員
 已認證
已認證
德國飛馳高能行星式球磨機亮相2021中國能源材料化學研討會
2021年4月2-4日,溫暖和煦的清明假期,由中國科學技術大學化學與材料科學學院和合肥微尺度物質科學國家研究中心共同主辦的“第五屆中國能源材料化學研討會”在安徽省合肥市順利召開。
本次研討會圍繞“能源材料化學”相關主題開展了廣泛的學術交流,對該領域的前沿研究方向進行了認真探討,帶來了領域發展的新動態。相關研究領域的專家、中國科大師生等800余人參加了此次會議,圍繞電化學儲能、催化、太陽能電池、碳材料、表征與計算等研究方向開展了廣泛而深入的學術討論,對能源材料領域未來的發展方向進行了展望。

儲能分會場中,廈門大學的楊勇教授、中國科學院的崔光磊教授、北京理工大學的陳人杰教授、清華大學賀艷兵教授等近200位教授專家,針對不同議題進行了專業的報告。
德國飛馳FRITSCH GmbH也攜帶王牌產品:納米級高能行星式球磨機Pulverisette 7加強型,參與了本次能源材料的盛會。

會議過程中,飛馳人驕傲又感動,儲能研究中邀請發言的專家學者幾乎都是飛馳的現有客戶。能夠用德國儀器,助民族科研騰飛,是飛馳最大的欣慰。
為什么眾多科研大牛選擇飛馳行星式球磨機進行能源樣品的納米化制備呢?

德國飛馳 2021-04-19 | 閱讀:3701
最新動態
更多
FRITSCH飛馳儀器球磨-制備新型銀銦合金膠材料
應用實例
2025-08-20

FRITSCH球磨-制備新型銀銦合金膠材料
應用實例
2025-08-20

FRITSCH飛馳粉碎、篩分——重礦物基礎研究環節把關
應用實例
2025-06-26

FRITSCH飛馳球磨——增材制造原料制備新方案
應用實例
2025-05-27




